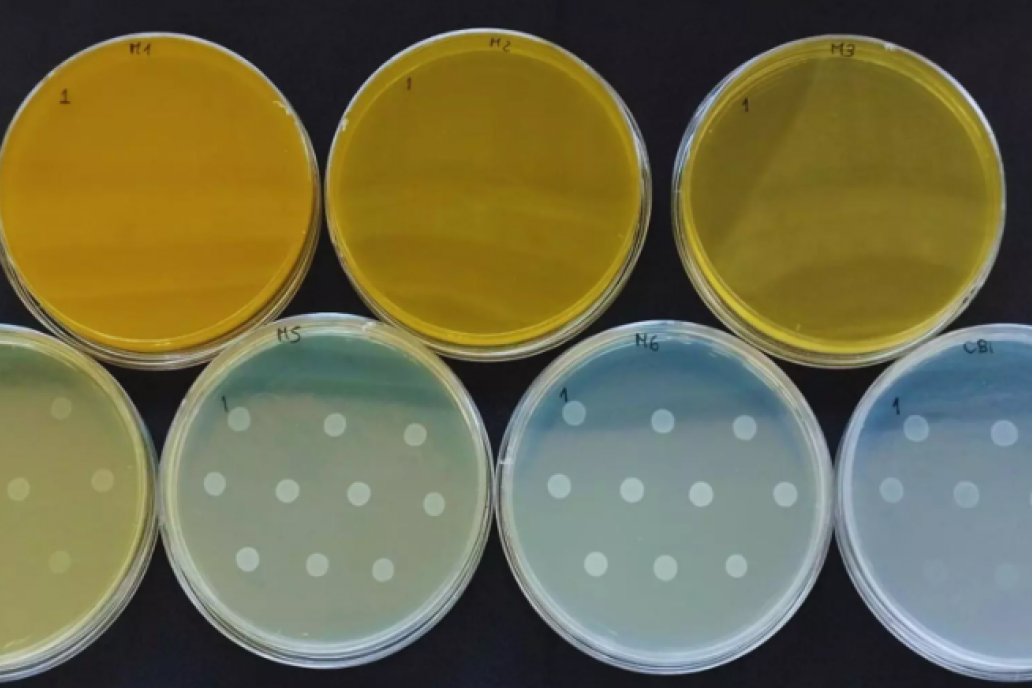

El avance de la resistencia a los antimicrobianos (RAM) es una de las principales preocupaciones globales, con impacto directo en la salud humana, la sanidad animal y el ambiente. Frente a este desafío, el sector agropecuario busca alternativas que permitan sostener la productividad sin comprometer la eficacia futura de los tratamientos.
En este marco, desde el Instituto de Patobiología Veterinaria del INTA-Conicet, evaluaron el potencial de aceites esenciales de inducir resistencia antimicrobiana, un riesgo clave a la hora de pensar en reemplazos de los antibióticos tradicionales. Los ensayos, determinaron que los compuestos analizados de orégano y canela no generaron clones resistentes ni alteraron la sensibilidad de las bacterias a los antibióticos utilizados en salud animal.
“Los datos sugieren que, incluso tras una exposición prolongada, las bacterias no desarrollaron resistencia a los aceites esenciales”, explicó Johana Domínguez, quien detalló que los fitoquímicos presentes en estos aceites son compuestos naturales que, usados de forma continua en la alimentación animal, pueden mejorar el rendimiento productivo, la calidad de los productos y, lo más importante, garantizar su inocuidad.
Estos beneficios se deben a la capacidad de los aceites esenciales para modular la microbiota intestinal, estimular las defensas naturales del animal y mejorar la digestibilidad de los alimentos, actuando además como antioxidantes.
Además de este hallazgo, distintos estudios en pollos de engorde evidencian beneficios productivos y sanitarios sobre el uso de estos compuestos. “La inclusión de cinamaldehído (compuesto responsable del sabor y aroma característicos de la canela) y carvacrol (presente en el orégano) en la dieta de pollos de engorde mejora la ganancia de peso corporal y contribuye a mantener sistemas productivos sostenibles”, señaló Natalia Casanova.
Según expresó Casanova, “estos compuestos, junto con probióticos y bacteriófagos, conforman un conjunto de soluciones de bajo impacto ambiental que permiten mantener sistemas productivos sostenibles sin comprometer la eficacia terapéutica futura”.
Envía tu comentario